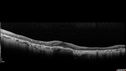
ga-jobau_031919_14~0.jpg

Concentric Geographic Atrophy - 76 YO male
|
|
76 year old man The patient has noticed that his vision is getting worse at night. The vision loss has come on gradually. He notices that his vision in low lighting is poor and at night with oncoming headlights.
VA OD: Dcc20/40-1 NscJ7
VA OS: Dcc20/40-1 NscJ7
IOP: TP: OD:17 OS:18 Time:12:01 PM
|

Concentric Geographic Atrophy - 76 year old man398 viewsGradual vision loss, worse at night. VA 20/40 OU.    
(0 votes)
|
|

Concentric Geographic Atrophy - 76 year old man400 viewsGradual vision loss, worse at night. VA 20/40 OU.    
(0 votes)
|
|

Concentric Geographic Atrophy - 76 year old man414 viewsGradual vision loss, worse at night. VA 20/40 OU.    
(0 votes)
|
|

Concentric Geographic Atrophy - 76 year old man421 viewsGradual vision loss, worse at night. VA 20/40 OU.    
(0 votes)
|
|

Concentric Geographic Atrophy - 76 year old man398 viewsGradual vision loss, worse at night. VA 20/40 OU.    
(0 votes)
|
|

Concentric Geographic Atrophy - 76 year old man393 viewsGradual vision loss, worse at night. VA 20/40 OU.    
(0 votes)
|
|

Concentric Geographic Atrophy - 76 year old man363 viewsGradual vision loss, worse at night. VA 20/40 OU.    
(0 votes)
|
|

Concentric Geographic Atrophy - 76 year old man414 viewsGradual vision loss, worse at night. VA 20/40 OU.    
(0 votes)
|
|

Concentric Geographic Atrophy - 76 year old man372 viewsGradual vision loss, worse at night. VA 20/40 OU.    
(0 votes)
|
|

Concentric Geographic Atrophy - 76 year old man409 viewsGradual vision loss, worse at night. VA 20/40 OU.    
(0 votes)
|
|
Concentric Geographic Atrophy - 76 year old man366 viewsGradual vision loss, worse at night. VA 20/40 OU.    
(0 votes)
|
|

Concentric Geographic Atrophy - 76 year old man379 viewsGradual vision loss, worse at night. VA 20/40 OU.    
(0 votes)
|
|

Concentric Geographic Atrophy - 76 year old man373 viewsGradual vision loss, worse at night. VA 20/40 OU.    
(0 votes)
|
|

Concentric Geographic Atrophy - 76 year old man420 viewsGradual vision loss, worse at night. VA 20/40 OU.    
(0 votes)
|
|

Concentric Geographic Atrophy - 76 year old man399 viewsGradual vision loss, worse at night. VA 20/40 OU.    
(0 votes)
|
|

Concentric Geographic Atrophy - 76 year old man429 viewsGradual vision loss, worse at night. VA 20/40 OU.    
(0 votes)
|
|
|
|
76 year old man The patient has noticed that his vision is getting worse at night. The vision loss has come on gradually. He notices that his vision in low lighting is poor and at night with oncoming headlights.
VA OD: Dcc20/40-1 NscJ7
VA OS: Dcc20/40-1 NscJ7
IOP: TP: OD:17 OS:18 Time:12:01 PM